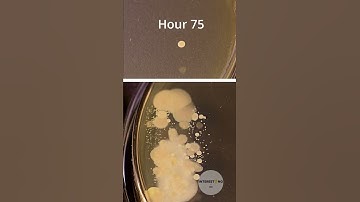
Washed vs dirty hands bacteria time lapse 🦠🧫 #bacteria #timelapse #shorts

⬇ DOWNLOAD NOW
Kalau muncul iklan pop-up, tutup lalu klik tombol kembali
Download lagu Making Agar.io in 2 HOURS!! // Developing Timelapse secara gratis hanya untuk keperluan promosi. Dukung artis favorit kamu dengan membeli musik original di iTunes atau platform resmi lainnya.
 "Agar.io Mobile: Then vs Now" #agariomobile #agario #agarioedit #agariomod
"Agar.io Mobile: Then vs Now" #agariomobile #agario #agarioedit #agariomod
 2 Hours Of Agario In 20 Seconds! (Agario Timelapse)
2 Hours Of Agario In 20 Seconds! (Agario Timelapse)
 This time-lapse was taken over 16 day from colonization to fruiting with a GoPro. 📷🍄
This time-lapse was taken over 16 day from colonization to fruiting with a GoPro. 📷🍄
 Nebulous.io #nebulous #shorts #agario #ballgame
Nebulous.io #nebulous #shorts #agario #ballgame
 Satisfying Agar.io Moment ( #agario #satisfying )
Satisfying Agar.io Moment ( #agario #satisfying )
 time lapse , garlic growing in soil for 10 days , PART 2 IN THE CHANNEL
time lapse , garlic growing in soil for 10 days , PART 2 IN THE CHANNEL
 The decay of apples in a earth worm box
The decay of apples in a earth worm box
Washed vs dirty hands bacteria time lapse 🦠🧫 #bacteria #timelapse #shorts
Washed vs dirty hands bacteria time lapse 🦠🧫 #bacteria #timelapse #shorts